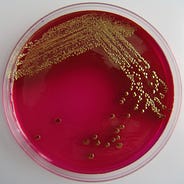
Faster Together Firooz Aflatouni S Electronic Photonic By Penn Engineering Penn Engineering Medium

Firooz Aflatouni
Firooz aflatouni received the phd.

Firooz aflatouni. Email to make an appointment. Firooz aflatouni associate professor electrical and systems engineering ese email research webpage. Received his bsc 2014. He started his phd in fall 2014 mohamad hossein idjadi.
Firooz aflatouni moore 201. 415pm 530pm or email to make an appointment. Firooz aflatouni skirkanich assistant professor in electrical and systems engineering will lead the project collaborating with scientists from stanford university the national institute of. Todays practical microwave imagers are bench top systems that are bulky and expensive said research team leader firooz aflatouni from the university of pennsylvania usa.
Mark allen singh 222. Our new near field imager uses optical rather than electronic devices to process the microwave signal. Firoozs research interests include high speed integrated circuits electronic photonic co design and silicon photonics with applications in imaging. Firooz aflatouni skirkanich assistant professor electrical and systems engineering.
Nader engheta moore 215. The first ever image of a black hole published in 2019 was constructed from five petabytes. Pratik chaudhari levine 470. Lee bassett levine 362.
Integrated circuits silicon photonics. Aflatounis left lab works to make the electronic and photonic components of our modern information delivery infrastructure work together. Firooz aflatouni 1 2 behrooz abiri 1 angad rekhi 1 and ali hajimiri 1. 1 department of electrical engineering california institute of technology pasadena ca 91125 usa 2 department of electrical and systems engineering university of pennsylvania philadelphia pa 19104 usa corresponding author.
Skirkanich assistant professor phd students. He was a post doctoral scholar in the department of electrical engineering at the california institute of technology before joining the university of pennsylvania in 2014 where he is skirkanich assistant professor in the department of electrical and. Andre dehon levine 270. Received his bsc 2011 and msc 2013 in electrical engineering from sharif univeristy of technology iran.